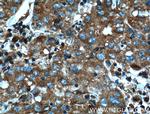
AHCYL1 Antibody in Immunohistochemistry (Paraffin) (IHC (P))

Search
Proteintech
AHCYL1 Polyclonal Antibody
{{$productOrderCtrl.translations['antibody.pdp.commerceCard.promotion.promotions']}}
{{$productOrderCtrl.translations['antibody.pdp.commerceCard.promotion.viewpromo']}}
{{$productOrderCtrl.translations['antibody.pdp.commerceCard.promotion.promocode']}}: {{promo.promoCode}} {{promo.promoTitle}} {{promo.promoDescription}}. {{$productOrderCtrl.translations['antibody.pdp.commerceCard.promotion.learnmore']}}
产品信息
10658-3-AP
种属反应
已发表种属
宿主/亚型
分类
类型
抗原
偶联物
形式
浓度
规格
纯化类型
保存液
内含物
保存条件
运输条件
产品详细信息
Immunogen sequence: IDRCVNMDG WQANMILDDG GDLTHWVYKK YPNVFKKIRG IVEESVTGVH RLYQLSKAGK LCVPAMNVND SVTKQKFDNL YCCRESILDG LKRTTDVMFG GKQVVVCGYG EVGKGCCAAL KALGAIVYIT EIDPICALQA CMDGFRVVKL NEVIRQVDVV ITCTGNKNVV TREHLDRMKN SCIVCNMGHS NTEIDVTSLR TPELTWERVR SQVDHVIWPD GKRVVLLAEG RLLNLSCSTV PTFVLSITAT TQALALIELY NAPEGRYKQD VYLLPKKMDE YVASLHLPSF DAHLTELTDD QAKYLGLNKN GPFKPNYYRY (212-530 aa encoded by BC007576)
靶标信息
The protein encoded by this gene interacts with inositol 1,4,5-trisphosphate receptor, type 1 and may be involved in the conversion of S-adenosyl-L-homocysteine to L-homocysteine and adenosine. Several transcript variants encoding two different isoforms have been found for this gene.
仅用于科研。不用于诊断过程。未经明确授权不得转售。
生物信息学
蛋白别名: adenosylhomocysteinase 2; AdoHcyase 2; DC-expressed AHCY-like molecule; DCAL; dendritic cell expressed AHCY-like protein; dendritic cell expressed AHCY-like protein; epididymis secretory sperm binding protein; inositol 1,4,5-trisphosphate receptor-binding protein; IP(3)Rs binding protein released with IP(3); IP3R binding protein released with inositol 1,4,5-trisphosphate; IP3R-binding protein released with inositol 1,4,5-trisphosphate; IRBIT; protein phosphatase 1, regulatory subunit 78; Putative adenosylhomocysteinase 2; s adenosylhomocysteine hydrolase; S-adenosyl homocysteine hydrolase homolog; S-adenosyl-L-homocysteine hydrolase 2; S-adenosylhomocysteine hydrolase, related sequence 3; S-adenosylhomocysteine hydrolase-like 1; S-adenosylhomocysteine hydrolase-like protein 1; similar to S-adenosylhomocysteine hydrolase; unnamed protein product
基因别名: 1110034F20Rik; AA409031; AA414901; Ahcy-rs3; AHCYL1; DCAL; IRBIT; PPP1R78; PRO0233; XPVKONA
UniProt ID: (Human) O43865, (Rat) B5DFN2, (Mouse) Q80SW1
Entrez Gene ID: (Human) 10768, (Rat) 362013, (Mouse) 229709